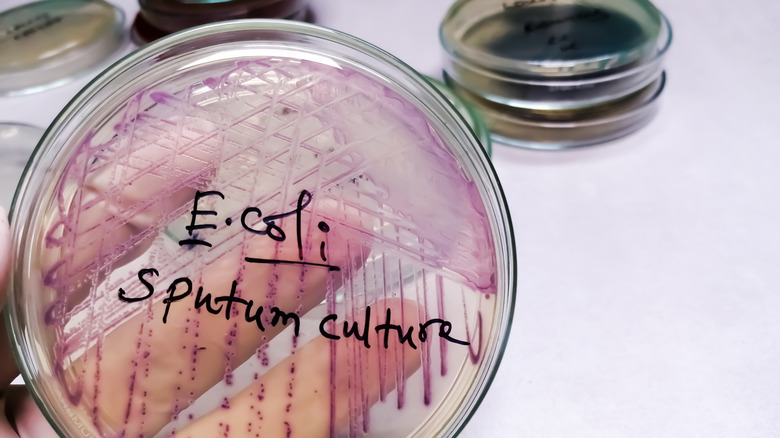
E. coli culture in glass dish.

One Of The Worst Wegmans Recalls Involved 1 Million Pounds Of Ground Beef
There are many reasons to love Wegmans. The grocery chain, which has stores in 10 states along the east coast of the United States, has grown a bit of a cult following. Customers love the chain's large selection of store brand items, welcoming store designs, and the resident train track set in the ceiling of most locations. On top of all of this, Wegmans has a wonderful selection of meats, cheeses, and baked goods. With all of that said, the chain is not without its own ups and downs. In January 2025, Wegmans recalled frozen chicken nuggets from stores due to the presence of bone pieces in the product.
However, that was small potatoes compared to an October 2007 ground beef recall that caused over 1 million pounds of ground beef to be pulled from store shelves due to a potential E. coli contamination. The recall impacted ground beef sourced from a Cargill Meat Solutions processing facility in Pennsylvania, but Wegmans wasn't the only grocer affected by this fiasco — other chains, such as Shop Rite, Giant, Weis, and Stop & Shop, were hit as well. Thankfully, this ground beef caused no publicly reported incidents of illness, and the contamination was caught by assessments done at the Cargill Meat Solutions plant by the United States Food and Drug Administration (USDA).
Why the Wegmans beef recall was so serious
Food recalls involving harmful bacteria, such as E. coli and Salmonella, aren't necessarily uncommon. However, the sheer scope of the Wegmans recall makes it notable, as it encompassed a large selection of the store's beef. The recall involved the strain of E. coli known as E. coli O157:H7. This strain of E. coli has the potential to cause severe symptoms in those who consume contaminated foods. The O157:H7 strain of E. coli was also responsible for some of the worst E. coli outbreaks in history.
This recall came shortly after another ground beef E. coli-related recall from a Wisconsin Cargill Meat Solutions facility, also in October 2007. It involved the same strain of E. coli, but was sourced from a different meat processing facility than the Wegmans case. In this situation, two parents later sued Cargill Meat Solutions following their daughter's bout with the bacteria-borne illness, which led her to need a kidney transplant. Kidney damage and kidney failure are both tied to severe E. coli infections, particularly STEC (Shiga toxin-producing E. coli), which is associated with the O157:H7 strain.
Safely inspect and handle raw ground beef
While E. coli and other foodborne illnesses are commonly associated with raw meat, some fruits and vegetables are often contaminated with E. coli as well. However, because ground beef is more processed than other cuts of beef, it tends to be at a greater risk of bacterial contamination. Grocery stores like Wegmans do their best to clear out old products, but it's always a good idea to check the sell-by or expiration date of the ground beef listed on the package.
Check for any signs of spoilage in your beef, such as an odd smell, discoloration, or change in texture. Even if your ground beef meets the criteria for freshness, dispose of any products that have been recalled. They can still pose a risk of infection through improper handling and cross-contamination at some point in the supply chain.
Once your fresh beef is ready to cook, continue with best practices for food safety, such as thoroughly washing your hands and sanitizing kitchen surfaces. Additionally, you should avoid rinsing raw meat, as it can further spread dangerous bacteria across your kitchen. When it comes to cooking fresh ground beef, make sure it reaches an internal temperature of 160 degrees Fahrenheit, which kills most strains of E. coli. With these tips in mind, you can safely purchase and cook your favorite ground beef at Wegmans.